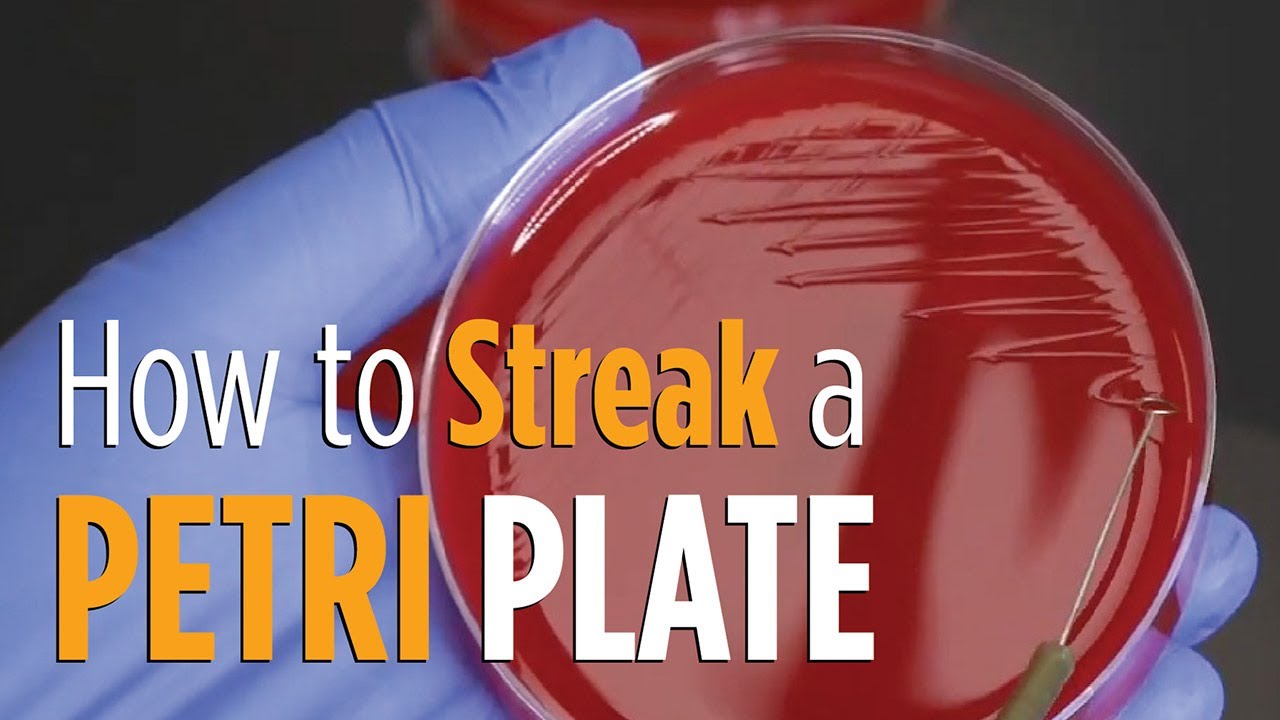
Four Quadrant Streak procedure - How to properly streak a Petri plate for isolated colonies

oi oi gente sejam muito bem-vindos novamente ao canal eu sou a Renata e no vídeo de hoje eu vou apresentar para vocês como é que a gente trabalha com esse equipamento tão legal que é um microscópio você curtiu assunto Bora para o vídeo E aí [Música] E aí Olá pessoal esse é o tipo de equipamento que a gente utiliza bastante na Ares e Laboratorial outros microscópios que são microscópios eletrônicos tem aumento bem maior a gente consegue observar estruturas Como os vírus outros microscópios como de florescência confocal de varredura várias outras tecnologias tá para que a
gente utiliza esse microscópio aqui basicamente pra gente analisar esses tipos de lâmina tá lâminas coradas por exemplo com grampo a gente observar a técnicas de colorações e analisar bactérias por exemplo sou fungos a gente utiliza para analisar de cá né que é a pesquisa do bacilo álcool-ácido resistente né que é o bacilo da tuberculose a mycobacterium tuberculoses curada com Nilce eu utilizo por exemplo esfregaço sanguíneo na Hematologia e utilizo por exemplo na citopatologia do cérvicovaginal então gente utiliza para analisar o Papa o e outras secreções diversas aí Tá além dessas lâminas normais eu também posso
utilizar nessa microscopia Ótica materiais a qual eu possa analisar com a câmera de newball então eu consigo analisar por exemplo células contidas no espermograma eu consigo analisar células contidas na urina consigo analisar é materiais de licor tá tudo através da Câmara de neubauer da câmera de fux são bem parecidas o que muda é a estrutura demarcação dessas câmeras tá então eu vou mostrar para vocês Quais são as estruturas do microscópio e depois a gente foca uma lâmina para que vocês possam analisar como que ele aumenta Quais são as características de aumente como que eu faço
para focar nesse microscópio resolver que é bem tranquilo então esse é um microscópio óptico normal ele é um big ocular ou se a gente consegue observar com os dois e existem microscópios óticos que a gente consegue ver com o olho só a gente tem que ficar assim que é os monoculares mas esse daqui dá para gente observar com os dois olhos então tem algumas pessoas que têm os olhinhos mais próximo do nariz e tem pessoas que têm os olhinhos Mais afastados e aí você pode modificar aqui no tubo para você acertar a o seu objetivo
de conforto tá para analisar as Lando Ok então vamos começar a falando das oculares tá aqui eu tenho oculares e cada o colar dessa é uma lente tá não deixa de ser uma lente Aqui nós temos uma marcação olha essa daqui por exemplo ela tem um aumento de dez vezes então a ocular ela já é um aumento tá Então essa daqui por exemplo 10 vezes e essa daqui 16 vezes sai uma ocular que aumenta um pouquinho mais então Observe que eu tenho uma lá e aqui eu vou ter uma outra lente aqui tá Então vamos
começar por aqui Essas são azul colares esse daqui é o tubo e esse daqui na lateral é o braço tá onde a gente utiliza para locomover caso necessário esse microscópio aí nós temos também uma parte extremamente importante tá que é o revólver TA gente chama ele de revólver que é onde você consegue modificar as objetivo cada objetiva observa em que ela tem uma coisinha diferente essa por exemplo tem um filete aqui vermelho essa tem um filete Amarelo essa tem um filete azul e ao objetivo de sentem dois filhotinhos um preto e um branco ou então
somente um branco tá então cada dessas objetivas também é uma lente Então se vocês forem pensar nós temos um e a qual possibilita o aumento da imagem eu tenho uma lente aqui e eu tenho uma lente aqui então como vocês estão vendo eu tenho aqui uma objetiva de 100 né e ela é uma lente de aumento de 100 vezes você já leu ampliassem vezes a imagem mas eu falei para vocês que as oculares também são lentes e aqui eu tenho 10 vezes então o tamanho ideal de aumento da imagem vai ser a multiplicação aqui ó
da lente que eu tenho aqui na ocular com a lente que eu tenho aqui na objetivo Então se aqui eu tenho 10 vezes eu vou multiplicar aqui por sem tá então eu tenho um aumento final quando eu observo nessa lente aqui nessa objetiva aqui de mil vezes Ok então confirmou mudando as oculares e vô rodando aqui ó as objetivas Eu tenho um modificação no tamanho das imagens e continuando a falar das objetivas essa vermelhinha que normalmente ela aumenta quatro vezes essas amarelinha ela aumenta 10 vezes essa azul 40 vezes e essa daqui a última que
é objetiva de imersão que a gente utiliza ela aumenta a 100 vezes importante dizer que essa objetiva de imersão ela só pode ser analisada com uma lubrificação que é chamado de óleo de imersão que quando a gente encosta a lâmina que prende a lâmina aqui e coloca essa objetivo aqui ela praticamente encostam a objetiva EA lâmina Então você precisa ser o óleo de imersão nas outras objetivas a gente não usa Óleo de imersão OK aí nós temos aqui a mesa ou a platina que é onde eu vou colocar a minha lâmina e aqui eu tenho
uma presilha tá onde eu vou pra é a minha plano Ok então ela está prezinho aqui beleza Além disso nós temos o chá rio que é esse aqui na lateral o quê que isso faz Renata isso proporciona que a mesa ande para frente e para trás assim como as laterais tá Então olha esse maior Zinho para frente para trás a mesa tá vendo vai para frente para trás e aqui no menorzinho vai para as laterais aí nós temos também a fonte de luz não temos como analisar nada microscopicamente falando se você não tiver uma luz
Então observa em que essa fonte de luz aqui nós temos o liga e desliga tá onde você pode aumentar também olha tá essa essa luminosidade tá e nós temos essa fonte de luz que vem de baixo para cima outra coisa que legal da gente analisar que aqui nós temos um condensador Ah tá quando você tem a imagem essa imagem ela é ampliada conforme a luz bate o condensador nada mais é do que o nome já tá dizendo ele vai conversar ele vai focar melhor essa luz tá ele vai é proporcionar com essa luz fique numa
única imagem tá ela não desperdice tanto então você pode subir ou descer esse condensador através de um botãozinho que a gente tem aqui ó tá então tá vendo sobe e desce tá então ele tá mais baixo essa luz tá mais ampliada a hora que você sobe ele para próximo da imagem essa luz ela vai focando melhor numa imagem só tá outra coisa que nós temos é o diafragma tá aqui também tem essa função de aumentar aqui ó tá essa luminosidade observa que aqui é chamado de macrométrico e aqui é chamado de micrométrico Ok quando você
coloca essa lâmina aqui e você Oi Nice macro observa em que a mesa ela sobe bem rápido tá ó ela sobe e desce bem rápido ao contrário do micrométrico Então é só vou descer até lá embaixo e vou mexer no micro observa em aqui essa mesa a gente quase não consegue observar ela subindo tá porque ela sobe bem lentamente e a gente utiliza mais por incrível que pareça o micrométrico do que o macrométrico depois que você teve o foco na sua lâmina Você quase não utiliza mais o Marco se utiliza a sua mente o micrométrico
Então agora eu vou colocar para vocês uma lâmina para que vocês possam observar a mudança das imagens ele tem alguns microscópios que já tem uma uma câmera acoplada no próprio microscópio É lógico que é muito mais fácil tá mas como eu não tenho esse esse esse a O que é próprio a gente utiliza um tá Eu encaixo aqui na ocular e depois eu coloco o meu celular aqui e eu consigo gravar as imagens nesse momento pessoal não sei se vocês observarem eu tô sem luva mas eu vou utilizar uma lâmina aqui de esfregaço sanguíneo e
como essa lâmina as células já estão fixadas aqui corada não existe problema de contaminação tá por isso que eu estou sem luva então eu escolhi essa dermatologia porque a gente consegue chegar até o momento de 100 vezes Ok ou melhor de mil vezes não esqueçam que é 10 x sem aqui caso eu escolha essa objetiva tá então eu vou colocar ele aqui fecho a minha presilha sempre à minha mesa tá lá embaixo sempre eu começo assim o foco que eu consigo regular a fonte de luz aqui mais luz menos luz no caso do esfregaço sanguíneo
A gente utiliza O Pensador mais para cima tá não muito lá para baixo Ok e o diafragma também e intermediário aberto sempre olhando aqui na as oculares e vou usar o macrométrico para achar o foco inicial sempre míssil pela objetiva de menor aumento [Música] o OK mas aí vocês observam que eu vejo várias bolinhas pequenininhas mas eu não consigo definir nada tô fazendo isso aqui é um esfregaço sanguíneo Então tem que ter pelo menos em março aí que eu consigo visualizar além dos leucócitos e das plaquetas mas nessa nesse nesse aumento eu não consigo visualizar
nada disso mas eu consigo observar que está focado consigo ver várias bolinhas pequenininhas Então a partir de agora eu não uso mais um macrométrico somente um micrométrico então o que que eu faço eu posso passar para uma objetiva de maior aumento ela vem aqui viro aqui o revólver Até chegar na objetiva um pouquinho maior tá que é objetivo aqui de 10 novamente observa aqui as oculares e vou mexendo no micro até acertar o foco E aí o ok conseguimos observar que essa imagem aumentou um pouco mas ainda não consigo definir quais são essas células novamente
só mexo no micro giro o revólver aqui para objetiva de 40 e dá sempre Midinho para saber se ela vai bater na lâmina mas ela não bate se estiver focada na objetiva de melhoramento tá aí Renata eu perdi o foco não tô conseguindo achar e tá volta de novo a mesa lá para baixo e inicia novamente com o objetivo de menor aumento ótimo nessa objetiva eu já consigo definir o que que aí Márcia o que que é leucócito mas na Hematologia Existem algumas inclusões eritrocitárias algumas características no leucócitos que eu consigo observar somente na objetiva
de 100 que é objetiva de imersão então o que que eu vou fazer agora preciso passar para Algum objetivo de 100 todo mundo morre de medo de as primeiras vezes mas se você garante que não objetiva de 40 está focado então você pode passar para o objetivo de 100 com óleo de nós são que elas não vão ter problema não vai quebrar e nem nada então vamos fazer esse procedimento agora pessoal eu tenho uma técnica que eu gosto de utilizar que eu sempre viro o revólver até a metade observa em que tem uma luzinha aqui
que essa imagem de luz que tá vindo de baixo para cima e fica uma bolinha aqui então eu venho com óleo de imersão o e Pingue uma gotinha não é 3 litros tá é uma gotinha pequena e aí eu termine de virar o revólver Até que esse óleo de imersão em poste não me objetiva de 100 um ok que que eu faço agora eu vou no micro óleo nas oculares até eu acertar o foco [Música] bom então aqui a gente já consegue observar as características das células das hemácias dos leucócitos das plaquetas tá na objetiva
de 100 ou seja nós temos objetivo é de sem aumento de 10 vezes aqui na ocular então observando então em um bases o tamanho dessas estruturas é legal a gente observá-lo o contorno Tá Então nesse caso eu vou fazer as contagens celulares no caso de esfregaços lá na cauda do esfregaço eu tenho até um vídeo que fala do esfregaço aqui vou deixar ele em casa aqui para vocês mas para eu analisar a lâmina com todo objetiva então é de 100 eu posso mexer no chá Rio para frente e para trás assim como para as laterais
e assim eu consigo analisar todas as estruturas contidas em toda a extensão da lâmina pessoal sempre depois que utilizo a objetiva com óleo de imersão eu preciso deixar o microscópio Lince porque senão ele pode impregnar escolhe dimensão pode impregnar nessa objetiva e ocasionar danos enfim ele como ele muito oleoso ele pode danificar essa objetiva tá então a gente sempre que termino de utilizar o microscópio a gente baixa a mesa até o final e tira a lâmina essa lâmina ela pode ser limpa também e pega um papel extremamente é absorvente e delicado limpo a objetiva [Música]
deixo sempre ele na objetiva de menor aumento baixo a luz e desliga o microscópio e bom e se você gostou desse vídeo então curte comenta aqui se inscreve aqui no canal ativo Sininho para que você possa receber mais notificações e a gente se vê no próximo vídeo tchau tchau E aí E aí E aí [Música]